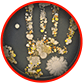

Προλάβετε!
Η προσφορά είναι περιορισμένη
Paratozol — προστατεύστε τον εαυτό σας από τους ελμίνθες!


Επικίνδυνα παράσιτα είναι παντού:

Ασφαλής
Φυσική σύνθεση χωρίς χημεία
Άμεσο
Άμεσος καθαρισμός
Αποτελεσματικό
Εγγυημένη αποκατάσταση
Η γνώμη του ειδικού

Κατερίνα Δοξάκη,
παρασιτολόγος
(13 χρόνια εμπειρία)
Το Paratozol δεν περιέχει χημικές ουσίες!


Εκχύλισμα από κράνο
Παραλύει τα παράσιτα. Έχει αντιφλεγμονώδεις και αντιοξειδωτικές ιδιότητες.


Εκχύλισμα από κολοκύθα
Δημιουργεί ένα περιβάλλον στο οποίο τα παράσιτα δεν μπορούν να επιβιώσουν.


Εκχύλισμα από μάραθο
Καταστρέφουν παθογόνους ιούς, προστατεύουν τα εσωτερικά όργανα.


Εκχύλισμα από παπάγια
Εξαλείφει τα σκουλήκια, καταπολεμά τις διεργασίες ζύμωσης στα έντερα.
H δράση του Paratozol είναι αξιόπιστη!
3 χρόνια
ανάπτυξης και ερευνών
10
πειραματικές
ομάδες
12-78 ετών
- η ηλικία των ατόμων
112 000
άτομα αξιολόγησαν τη δράση των χαπιών
Αποτελεσματικότητα
της χρήσης

Εντεροβίωση

Ασκαρίδωση

Τριχοκεφαλία

Αγκυλοστομίαση

Μικτή ελμινθίαση
Χρήση και
δοσολογία
Χρησιμοποιήστε τη δοσολογία
που ορίζει ο ειδικός τηλεφωνικός σύμβουλος
Ακολουθήστε την χρήση
λαμβάνοντας υπόψη την βελτίωση της υγείας σας και τα επιμέρους χαρακτηριστικά
Κάντε τη χρήση στο σπίτι χωρίς συνταγή
φυσική σύνθεση, χωρίς παρενέργειες
Παράδοση και πληρωμή
Συμπληρώστε την απλή αίτηση

Καθορίστε τις λεπτομέρειες με τον ειδικό μας σύμβουλο

Πληρώστε με αντικαταβολή

Ακολουθήστε τις οδηγίες
Προλάβετε!
Η προσφορά είναι περιορισμένη
Άννα 47 ετών
Το στομάχι δεν με ενοχλούσε ποτέ πριν. Δεν έτρωγα τίποτα ασυνήθιστο και ξαφνικά εμφανίστηκαν πόνοι και φούσκωμα. Ο γιατρός μου είπε ότι έχω παράσιτα και μου σύστησε το Paratozol για αγωγή και μετέπειτα πρόληψη. Όλα έχουν γίνει όπως πριν!
Γιάννης 79 ετών
Όσο μεγαλώνουμε , τόσο πιο υπερευαίσθητοι γινόμαστε στις αλλαγές Είναι αδύνατο να δούμε τα παράσιτα, αλλά σύντομα μετά τη μόλυνση νιώθω μια φαγούρα. Αυτό είναι αδύνατο να το ανεχτώ, οπότε έχω πάντα μαζί μου το ασφαλές σκεύασμα- Paratozol.
Βιβή 29 ετών
Μου αρέσει πολύ να τρώω σούσι και τώρα έχω ελμίνθες (αφού περιέχει ωμό ψάρι). Έχω θεραπευτεί με το Paratozol. Δεν μπορώ να απομακρυνθώ εντελώς από το αγαπημένο μου φαγητό, γι 'αυτό πίνω αυτά τα χάπια περιοδικά για να προστατεύσω τον εαυτό μου.